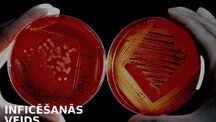
Презентация 'Infekcijas slimības: Mēris (Yersinia pestis)', 4.

-
Infekcijas slimības: Mēris (Yersinia pestis)

-
Infekcijas slimības: Mēris (Yersinia pestis)
Средняя школаПрезентация17 -
Seksuāli transmisīvās slimības
Средняя школаПрезентация24 -
Seksuāli transmisīvās slimības
Средняя школаПрезентация13
Infekcijas slimības: Mēris (Yersinia ...
Размер файла:
21525 KB
Идентификатор:
1407952